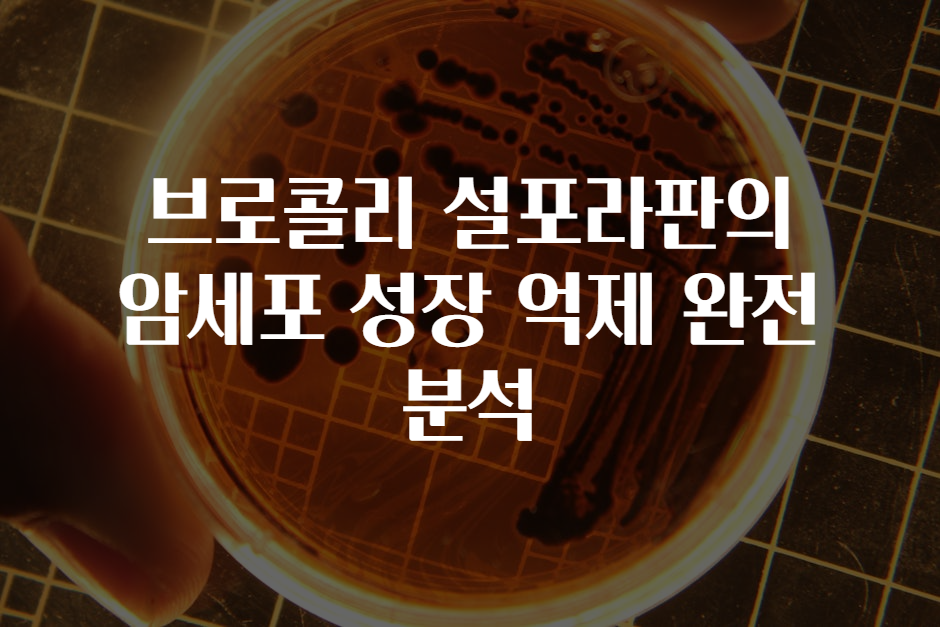

🧬 브로콜리 설포라판의 암세포 성장 억제 완전 분석 🌱🧪
🧐 왜 이 주제에 관심이 쏠릴까? ✨
혹시 건강하고 활기찬 삶을 위해 무엇을 먹어야 할지 고민하셨나요? 🤔 오늘은 친근한 채소인 브로콜리 속 보물, 바로 ‘설포라판’이 암세포 성장 억제에 얼마나 강력한 역할을 하는지 전문가의 시선으로 꼼꼼히 살펴볼게요! 🍽️💚

🌳 설포라판이란? 핵심 정보 한눈에! 🔑
✅ 설포라판(Sulforaphane) 은 브로콜리와 양배추, 십자화과 채소에 자연스럽게 존재하는 유효성분입니다. 🥦🥬
✅ 특징: 강력한 항산화 성분으로, 신체 내 독성물질 제거와 세포 건강 유지에 도움 💪🛡️
✅ 생성 과정: 브로콜리의 시포레인 글루코시놀레이트가 파괴되면서 설포라판으로 변환돼요! 🔀🌿
🔍 설포라판이 암 세포를 어떻게 억제하는지, 전문가 분석! 🧑🔬
암은 우리 몸의 세포들이 무분별하게 증식하는 병입니다. 🚫🦠 설포라판은 이 과정을 여러 가지 방법으로 차단하는데, 그 메커니즘을 체크리스트 형식으로 정리했어요! ✅🎯
1. 산화 스트레스 감소 & 세포 보호 🛡️✨
- 활성 산소(ROS)를 제거하여 유전물질(DNA) 손상 방지
- Nrf2 경로 활성화 → 항산화 효소(phase II detoxification enzymes) 증가 🔄🧬
- ⭐ 핵심 포인트: 세포를 산화로부터 보호하는 ‘보안 시스템’ 강화
2. 암세포 성장 억제 및 세포사멸 유도 🚨💥
- 세포 주기 조절: 암세포의 증식을 멈추거나 세포사멸(apoptosis)을 유도
- 신호 전달 차단: 암 성장에 관여하는 ‘PI3K/Akt’, ‘MAPK’ 경로 저해
- ⭐ 핵심 포인트: 설포라판은 암의 “멈춰!” 메시지를 보내는 역할! 🛑
3. 유전자 발현 조절 📜🔧
- 암 유전자 (Oncogene) 발현 억제
- 암 억제 유전자 (Tumor suppressor gene) 활성화
- ⭐ 핵심 포인트: 유전자를 ‘켜고 끄는’ 힘을 발휘하여 암 진행을 막음!
4. 염증 반응 낮춤 🔥❌
- 만성 염증은 암 유발 주요 원인! 🦠🤢
- 설포라판은 NF-κB 경로를 억제해 염증 반응을 줄여줍니다!
- ⭐ 핵심 포인트: ‘염증의 불씨’를 끄는 것, 바로 설포라판의 역할!
🧪 설포라판의 항암 효능, 과학적 근거와 연구 사례 🔬
🔥 최신 연구 결과에 따르면, 설포라판은 여러 유형의 암에서 긍정적 효과를 보여줍니다! 🎉
- 유방암: 암세포 증식 억제 및 세포사멸 유도 🌸
- 전립선암: 암 성장 억제와 함께 정자 건강에도 도움 💧
- 대장암: 피부암 예방 및 염증 반응 완화 🧻
- 폐암: 독성물질로부터 폐 세포 보호 🚬❌
🔍 과학 논문과 실험 사례를 보면, 설포라판은 암세포의 증식을 막는 핵심 자연 성분임이 입증되어 가고 있습니다! 📊📚
🌱 설포라판을 섭취하는 방법과 팁! 🥗🥢
✅ 설포라판 섭취 효율 높이기 위한 실천법 체크리스트! 📝
- 날것이나 살짝 데친 브로콜리 섭취 🍽️
- 생즙이나 스팀으로 조리하면 성분 파괴 최소화!
- 신선도가 최고! 🔥
- 유통기한 지난 채소보다 신선한 채소 선택하기
- 아이디어 레시피 활용하기 🍲🍹
- 브로콜리 샐러드, 스무디, 볶음요리 등 다양한 방법!
- 보충제 또는 건강기능식품 활용 🎯
- 설포라판 추출보충제 선택 고려! (단, 신뢰성 체크✅)
- 기름과 함께 먹기 🥥
- 유성 성분과 결합하면 흡수율 상승! (예: 올리브유, 참기름)
⭐ 특별 팁!
- 파인애플과 함께 먹기: 소화를 돕고, 항염 성분과 시너지 효과!
- 아침 식사에 포함: 하루 시작을 건강하게! ☀️
🚧 설포라판 섭취 시 주의할 점! ⚠️
- 과잉 섭취: 배탈, 소화불량 유발 가능! 적당량 섭취 필수 🚫
- 약물 복용자: 혈액 희석제 복용 시 전문가 상담 요망 💊
- 임산부, 수유부: 섭취량 조절 필요! 의사 상담 추천 👶
- 신선도 유지: 냉장 보관을 꼭! 🌡️
🔄 설포라판으로 실천하는 건강 지키기! 🌟
✅ 일상에 적용하는 실천 체크리스트!:
- 🥦 매일 최소 한 번은 브로콜리 섭취하기
- 🧑🍳 새로운 브로콜리 레시피 도전!
- 💪 운동과 함께 유익한 식단 병행
- 🧘♂️ 스트레스 줄이기, 충분한 수면하기!
- 📱 건강 관련 앱으로 섭취량 기록하기
🏁 결론: 설포라판, 우리 모두의 건강 파트너! 🌱🎉
- 핵심 정리: 설포라판은 강력한 항암 효과와 항산화 작용으로 암 예방과 치료에 도움을 줄 수 있는 자연성분입니다! 🧪🌟
- 실천 포인트: 신선한 브로콜리를 꾸준히 섭취하고, 다양한 요리법으로 식탁에 올려보세요! 🍽️🥗
- 미래 전망: 더 많은 연구와 임상시험이 진행되면서, 설포라판이 글로벌 건강 슈퍼푸드로 자리 잡아갈 전망입니다! 🚀🌍

🌈 오늘도 건강한 선택으로 삶을 더 활기차게! 🥦✨ 암 예방의 작은 시작, 바로 ‘설포라판’이랍니다! 😍🧬
이전 글 보기!!
위궤양 환자라면 알아야 할 생강의 위험성 위산 분비 증가 메커니즘 해부
📝 위궤양 환자가 알아야 할 생강의 위험성! 위산 분비 증가 메커니즘 해부 🎯🎉 여러분은 생강이 건강에 좋다고 들었지만, 혹시 위궤양이 있는 분들은 조심해야 한다는 사실을 알고 계셨나요
4.asmrbita.com
식도염 있어도 마늘의 효능만 누리는 7가지 특별 조리 테크닉
🌟 식도염 있어도 마늘의 효능만 누리는 7가지 특별 조리 테크닉 🌟여러분, 혹시 "마늘 먹으면 속이 쓰리고 식도염이 걱정돼서 못 먹겠어요"라는 걱정을 한 번쯤은 해보셨나요? 😰 그런데 놀랍
4.asmrbita.com
'건강정보' 카테고리의 다른 글
| 다이어트에 실패하는 이유가 식사 속도에 있다는 사실 아시나요 (0) | 2025.05.04 |
|---|---|
| 철분 흡수율 3배 높이는 7가지 시금치 기름 볶음 비법 (3) | 2025.05.04 |
| 아연 과다섭취가 오히려 면역력을 떨어뜨린다는 사실 알고 있나요 (3) | 2025.05.04 |
| 3배 강화된 면역력 비밀 에키네시아의 인터루킨8 증가 메커니즘 (0) | 2025.05.04 |
| 위궤양 환자라면 알아야 할 생강의 위험성 위산 분비 증가 메커니즘 해부 (0) | 2025.05.03 |